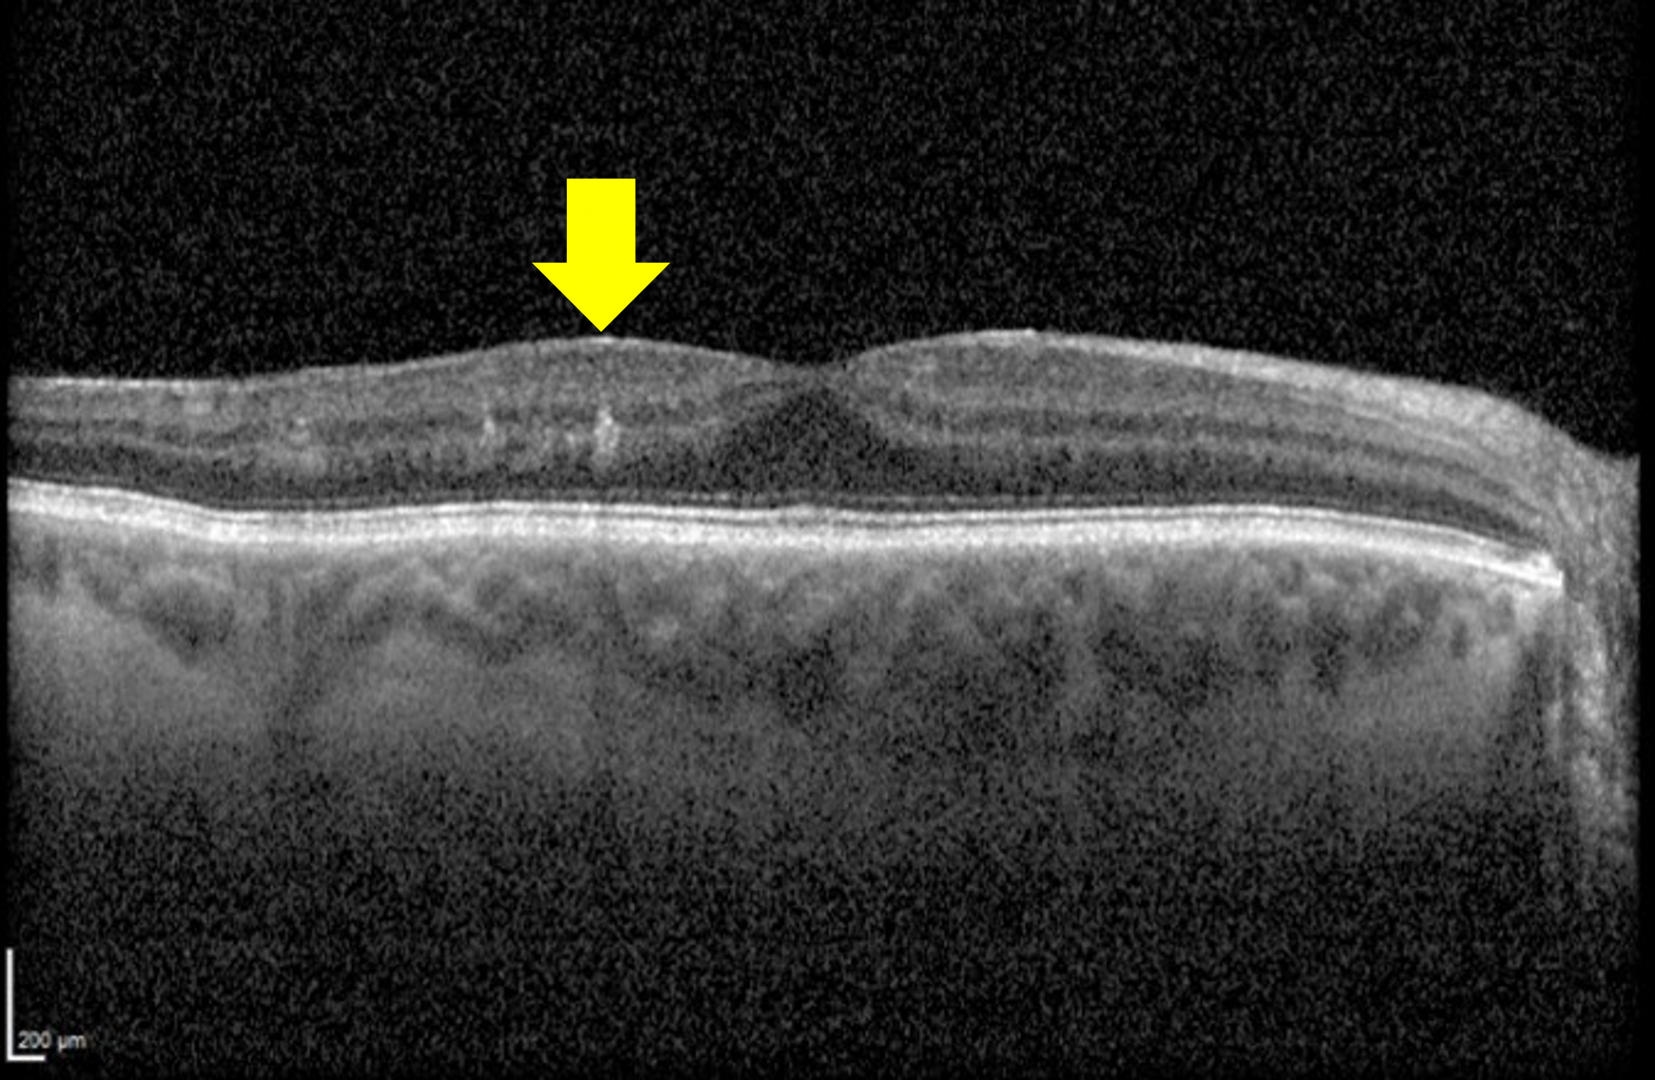

Overview

Diabetes causes a breakdown of the endothelial cell-cell junctions, a thickening of the basement membrane and eventually an occlusion of the retinal capillaries, resulting in poor perfusion of the macula.
Early macular ischaemia may precede clinically visible diabetic retinopathy (Takase, Retina 2015). Macular ischaemia is difficult to detect on funduscopy, however OCT Angiography (OCTA) allows detailed visualisation of the retinal capillary network and areas of non-perfusion.
OCTA signs of macular ischaemia include an enlargement of the foveal avascular zone (FAZ) and areas of paramacular capillary non-perfusion. As macular ischaemia progresses, the FAZ size increases and more areas of capillary non-perfusion arise.
Ischaemia may also occur in other areas of the retina, again due to capillary dropout. Intraretinal microvascular abnormalities (IRMA) and neovascularisation elsewhere (NVE) typically develop adjacent to areas of retinal ischaemia. NVE may lead to sight-threatening consequences such as retinal detachment and pre-retinal and/or vitreous haemorrhage as discussed elsewhere in this resource (select the tab "proliferative diabetic retinopathy" at the bottom of this page for further information).
It is important to also note however that macular ischaemia by itself is also a potential cause of vision loss.
OCT Signs
Recent studies have identified a clinical finding termed DRIL (disorganization of the retinal inner layers), which is used to describe poorly-defined boundaries of key inner retinal structures including the ganglion cell layer-inner plexiform layer (GCL-IPL) complex, inner nuclear layer (INL), and outer plexiform layer (OPL).
DRIL affecting more than 50% of the central 1-mm area of the retina is considered clinically significant. DRIL typically occurs in the central subfield of the ETDRS grid, and studies have shown that a 300 µm increase in DRIL is associated with a 1-line reduction in acuity.
The presence of DRIL has high diagnostic accuracy for identifying areas of non-perfusion (sensitivity 84.4%, specificity 100%). It is important to note however that not all areas of non-perfusion show signs of DRIL.
Case Examples
-
Case 1: Retinal ischaemia, intraretinal microvascular abnormalities (IRMA) and neovascularisation elsewhere (NVE)
A 39-year-old male with type 2 diabetes, diagnosed 5 years previously. He reports his HbA1c to be "high" but is unsure of the number. He also has untreated systemic hypertension. His best corrected visual acuity in the right eye is 6/6 (20/20). This case will focus on the right eye only.
-
Case 2: Severe retinal ischaemia
A 28-year-old male with type 1 diabetes, diagnosed at the age of 14. His most recent HbA1c was 8.4% and best corrected visual acuity is 6/6 (20/20) in each eye.
-
Case 3: Retinal ischaemia and DRIL
82 yo male with history of bypass heart surgery over 20 years ago and diagnosis of type 2 diabetes with recent HbA1c levels of 7%. Previous smoker, quit 12 months previous. VA OS 6/12-2 (pinhole 6/12+)
Differential Diagnosis
References
Duh, E. J., Sun, J. K., & Stitt, A. W. (2017). Diabetic retinopathy: current understanding, mechanisms, and treatment strategies. JCI insight, 2(14).
Johannesen, S.K., Viken, J.N., Vergmann, A.S. and Grauslund, J. (2019), Optical coherence tomography angiography and microvascular changes in diabetic retinopathy: a systematic review. Acta Ophthalmol, 97: 7-14.
Tran, Khoi; Pakzad-Vaezi, Kaivon (2018) Multimodal imaging of diabetic retinopathy, Current Opinion in Ophthalmology: November - Volume 29 - Issue 6 - p 566-575
Tripathi, Alka; Gaur, Shagun; Agarwal, Richa; Singh, Neha; Singh, Amit; Parveen, Shadman; Singh, Nivedita; Rima, Nani. Disorganization of retinal inner layers as an optical coherence tomography biomarker in diabetic retinopathy: A review. Indian Journal of Ophthalmology 73(9):p 1245-1250, September 2025.